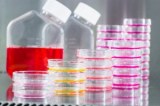

Chez Biovalley, nous sommes guidés par notre mission : Garantir que chaque patient atteint d'un cancer bénéficie du traitement approprié. C'est pourquoi nous collaborons avec les entreprises biopharmaceutiques pour faire progresser leurs programmes de recherche préclinique, translationnelle et clinique. Forts de notre expérience en oncologie et immuno-oncologie, nous exploitons les possibilités infinies qu’offre l’innovation scientifique.
Nos capacités répondent au besoin croissant d’études de preuve de concept pour des approches thérapeutiques et des médicaments innovants en oncologie et immuno-oncologie. Si le modèle parfait n’existe pas, nous pouvons en développer un sur mesure en collaboration avec vous.
Les services de Biovalley couvrent tous les types de thérapies, notamment les petites molécules, les anticorps, les conjugués anticorps-médicaments (ADCs), les anticorps bispécifiques, les nouvelles entités biologiques (oligonucléotides, peptides, protéines), les thérapies cellulaires, les radiothérapies, les vaccins, les vecteurs viraux et microbiens. Découvrez des solutions spécifiques adaptées à votre stratégie thérapeutique.
Services CRO en oncologie : R&D, Préclinique et Clinique
Accélérez le développement de vos thérapies oncologiques grâce à une CRO optimisée pour les traitements personnalisés. Des équipes et technologies à votre service, des capacités étendues et une expertise approfondie en oncologie vous accompagneront tout au long du processus, depuis les molécules prometteuses jusqu’à l’impact sur les patients.